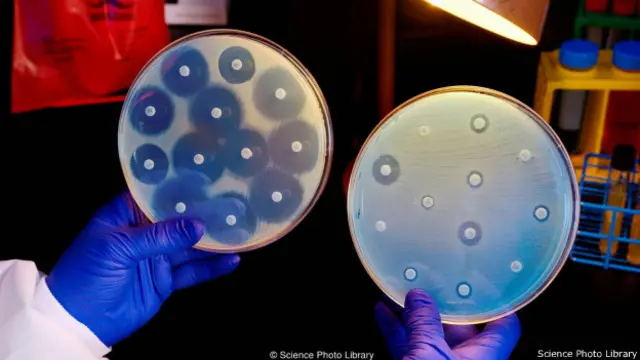
आर्कटिक समुद्र तल

क़ुदरत के पास है हमारे कई मर्ज़ों की दवा

इमेज स्रोत, David Wolman
- Author, डेविड वोल्मैन
- पदनाम, बीबीसी फ़्यूचर
क्या आपको पता है कि इंसानियत आज बहुत बड़ी चुनौती का सामना कर रही है. ये चुनौती है बीमारियों की. कैंसर और दिल की बीमारियों की. डायबिटीज़ और बैक्टीरिया के इन्फ़ेक्शन की. तमाम तरह के दर्द की, भूलने वाले मर्ज़ अल्झाइमर से निपटने की, वायरस से होने वाली बीमारियों से निपटने की चुनौती.
विज्ञान ने आज बहुत तरक्क़ी कर ली है. मगर, फिर भी इंसान अक्सर लाचार नज़र आता है. इन बीमारियों के आगे घुटने टेकता मालूम होता है. वजह ये कि बहुत से ऐसे मर्ज़ हैं जिन पर जीत हासिल करने की दवाएं नहीं खोजी जा सकी हैं.
इनके अलावा बहुत सी ऐसी दवाएं जो पहले तमाम मर्ज़ों से लड़ने में कारगर थीं, वो अब बेअसर साबित हो रही हैं. जैसे कई तरह के कीटाणुओं पर कारगर, एंटीबायोटिक दवाएं अब बेअसर साबित हो रही हैं. इसी तरह मलेरिया और डेंगू जैसी बीमारियों से लड़ने के लिए इंसान को नई दवाओं की ज़रूरत है.
विज्ञान की तरक्क़ी और दवा कंपनियों के अथाह फंड की बदौलत, लोग ये सोचने लगे थे कि वो तमाम बीमारियों से लड़ने की दवाएं लैब में विकसित कर लेंगे.

इमेज स्रोत, David Wolman
इस सोच को कुछ कामयाबी भी मिली जब कई गंभीर रोगों से लड़ने के लिए कंपाउंड या कई तत्वों के मेल से बनी दवाएं, प्रयोगशालाओं में तैयार कर ली गईं.
मगर सच तो ये है कि इंसान की ये सोच बुरी तरह नाकाम साबित हुई है. बरसों की मेहनत के बाद जब कई दवाएं तैयार हुई हैं, तब तक तो मर्ज़ का रूप-रंग ही बदल चुका होता है.
तरक्क़ी की तेज़ रफ़्तार में हम एक बुनियादी बात से मुंह मोड़ बैठे हैं. बुनियादी बात ये है कि हमारी बहुत सी मुश्किलों का हल क़ुदरत के पास है. हमारे कई मर्ज़ों की दवा क़ुदरत मुहैया करा सकती है. बल्कि सदियों से ऐसा होता आया है.
हमारी कमोबेश हर परेशानी का हल, हमें क़ुदरत से मिला है. आदि मानव के दौर में पत्थर के बने हथियार हों, खाना पकाने के लिए लकड़ी हो या फिर, खाने-पीने की ज़रूरत की चीज़ें, क़ुदरत हमारे हर सवाल का जवाब देती रही है. सदियों से इंसानी सभ्यता, क़ुदरती तरीक़ों से अपनी बीमारियों का इलाज करती रही है.

इमेज स्रोत, Alamy
हमारे पुरखे बहुत सी हर्बल दवाओं के जानकार थे. यहां तक कि आज भी कई रोगों से लड़ने की दवाएं हमें प्रकृति से हासिल होती हैं. जैसे कैंसर के इलाज के लिए होने वाली कीमोथेरेपी में इस्तेमाल होने वाली दवाएं डोसेटैक्सेल और पैक्लिटैक्सेल. ये दोनों ही केमिकल हमें यू या सदाबहार के पेड़ से मिलते हैं.
अपने तमाम मर्ज़ो से निपटने के लिए इंसान ने एक बार फिर क़ुदरत का रुख़ किया है. जंगलों में, पहाड़ों पर, ज़मीन के भीतर या फिर समंदर के अंदर, ऐसे केमिकल तलाशे जा रहे हैं, जो रोगों से लड़ने में हमारी मदद कर सकें.
ऐसी ही तलाश शुरू की है उत्तरी यूरोपीय देश नॉर्वे ने. यहां के ट्रॉम्सो शहर की यूनिवर्सिटी ने वहां की सरकार और निजी कंपनियों के साथ मिलकर पोलर रिसर्च सेंटर खोला है.
इसी के तहत बायोडिस्कवरी कार्यक्रम चलाया जा रहा है. इसके तहत, ध्रुवीय इलाक़ों में पाए जाने वाले जीवों, जैसे घोंघे, केकड़ों, जेली फ़िश या फिर हाइड्रा और काई की तमाम नस्लों के बीच पड़ताल करके ऐसे नए केमिकल तलाशे जा रहे हैं, जो किसी मर्ज़ से लड़ने में इंसान की मदद कर सकें.

इमेज स्रोत, David Wolman
इस अभियान के तहत काम करने वाले लोग आर्कटिक सागर में जाकर, सर्द माहौल में रहने वाले जीवों को जमा करते हैं. फिर उन्हें लाकर, ट्रॉम्सो यूनिवर्सिटी की लैब में परखा जाता है. उनमें, इंसान के मददगार साबित हो सकने वाले केमिकल तलाशे जाते हैं. इस काम में कई युवा वैज्ञानिक और कई तजुर्बेकार लोग लगे हुए हैं.
नॉर्वे बेहद ठंडा देश है. इसके इर्द-गिर्द बर्फ़ और समंदर के सर्द पानी का घेरा है. यहां का मौसम कभी-कभी इतना भयानक होता है कि जीना मुश्किल हो जाए. इस सर्द माहौल में भी ख़ुद को बचा पाने वाले जीवों, वो चाहे छोटे-बड़े जानवर हों या फिर पेड़ पौधे, में कुछ न कुछ तो ख़ास ताक़त होती है. जिनकी मदद से वो इतने बुरे माहौल में भी हज़ारों, लाखों साल से रह रहे हैं.
असल में धरती के अलग-अलग हिस्सों में एक से एक ख़राब मौसम मिलते हैं. ध्रुवों के क़रीब वाले इलाक़े बेहद सर्द होते हैं. मगर यहां भी कई तरह के जीव मिल जाते हैं. उनमें से ज़्यादातर समंदर के भीतर ही मिलते हैं.
नॉर्वे तो वैसे भी समंदर में मिलने वाले तेल के ख़ज़ाने की बदौलत ही आज दुनिया के सबसे अमीर मुल्क़ों में शामिल है. अब नया दौर है इसलिए अब समंदर की मदद से अमीरी का नया रास्ता तलाश रहे हैं नॉर्वे के लोग. क़ुदरत इस काम में उनकी मददगार हो सकती है.

इमेज स्रोत, David Wolman
पिछले क़रीब सौ सालों से लैब में तमाम तरह के रोगों की दवाएं विकसित करने की होड़ सी लगी है. मगर, तमाम दावों से इतर, सच तो ये है कि पिछले चालीस साल में जो भी नई दवाएं बाज़ार में आई हैं, उनमें से ज़्यादातर क़ुदरत से हासिल की गई हैं.
अमरीकी नेशनल कैंसर इंस्टीट्यूट के डेविड न्यूमैन कहते हैं कि प्रयोगशाला में बिना किसी क़ुदरती चीज़ के, कुछ बनाने की कोशिश बुरी तरह नाकाम हुई है.
वो सवाल उठाते हैं कि आख़िर हम क़ुदरत से क्यों मुंह मोड़ रहे हैं? यहां चीज़ें तीन सौ करोड़ साल के वक़्त की आंच में तपकर निखरी हैं. प्रकृति में पाए जाने वाले तमाम केमिकल को तलाश करके हम बहुत सी बीमारियों पर जीत हासिल कर सकते हैं.
यही वजह है कि अब ध्रुवों के क़रीब के सर्द समंदर से वो जादुई केमिकल तलाशने की कोशिश की जा रही है जो आज के दौर के मुश्किल रोगों से लड़ सकें. उन्हें ख़त्म कर सकें.
ब्रिटेन की एबरडीन यूनिवर्सिटी के मार्सेल जैस्पर कहते हैं कि लोग पूछते हैं कि फलां मर्ज़ का तोड़, क़ुदरत के पास क्यों नहीं? तो उसका जवाब ये है कि प्रकृति के पास तो हर सवाल का जवाब है. ज़रूरत उसे तलाशने की है.

इमेज स्रोत, Alamy
वैसे, नए कंपाउंड और नई दवाओं के लिए समंदर को खंगालने का चलन ज़्यादा पुराना नहीं. आज से बीस साल पहले तक लोग समुद्री जीवों के बारे में यही जानकारी जुटाते थे कि कौन से जीव इंसान को नुक़सान पहुंचा सकते हैं. किनसे बचकर रहने की ज़रूरत है.
90 के दशक से समुद्र को नई दवाओं का ख़ज़ाना मानकर देखा जा रहा है. आज की तारीख़ में समुद्र से क़रीब 24 हज़ार नए केमिकल तलाशे जा चुके हैं. इनकी ख़ूबियों की पड़ताल होनी बाक़ी है.
वैसे अब तक ऐसे 11 कंपाउंड पाए गए हैं जो कैंसर से लड़ सकते हैं. वैज्ञानिकों को लगता है कि लैब में नई दवाएं बनाने के बजाय अगर हम समुद्र को खंगालें तो हमारी बहुत सी बीमारियों का इलाज मिल सकता है. इनके अलावा इंसान के काम आने वाली और भी बहुत सी चीज़ें समुद्र में मिलने की उम्मीद है.
अफ़सोस की बात बस ये है कि अब तक समुद्र में पाए जाने वाले केवल एक फ़ीसद बैक्टीरिया की ख़ूबियों के बारे में इंसान को जानकारी है. लेकिन, नई चुनौतियों को देखते हुए, अब समंदर के अंदर इनके हल तलाशे जा रहे हैं.

इमेज स्रोत, Alamy
इस विचार पर यक़ीन रखने वाले दुनिया भर के वैज्ञानिकों में शामिल हैं नॉर्वे के ट्रॉन्ड योर्गेंसन. उन्होंने 1980 में नार्वे के मछली उद्योग को भारी तबाही से बचाया था.
तब नॉर्वे के क़रीब मिलने वाली साल्मन मछलियां रहस्यमयी ढंग से मर रही थीं. इनका कारोबार नार्वे की अर्थव्यवस्था का बड़ा हिस्सा था. योर्गेंसन और उनके साथियों ने साल्मन के मरने की वजह का पता किया और फिर उस रोग से लड़ने की वैक्सीन तैयार की.
1999 में योर्गेंसन की मुलाक़ात नार्वे की रिसर्च काउंसिल के एक सदस्य से हुई. उन्होंने साल 1969 का एक क़िस्सा सुनाया. जब एक स्विस वैज्ञानिक ने नॉर्वे के जंगलों से एक ख़ास तरह के कुकुरमुत्ते की नस्ल को खोजा. उसमें से एक केमिकल मिला, जिसका नाम है सिक्लोस्पोरिन.
ये आज की तारीख़ में तमाम तरह के ट्रांसप्लांट के मरीज़ों के काम आता है. इसे, उस कुकुरमुत्ते की नस्ल से निकालकर सैंडोज़ नाम की दवा कंपनी ने अरबों डॉलर कमाए. वहीं नार्वे के लोगों को इससे रत्ती भर भी फ़ायदा नहीं हुआ.
इमेज स्रोत, Science Photo Library
नॉर्वे की रिसर्च काउंसिल के उस सदस्य ने योर्गेंसन से कहा कि क्या हम अब भी अपने देश में ऐसे केमिकल तलाश सकते हैं, जो रोगों से लड़ने की ताक़त रखते हों.
योर्गेंसन ने इसका जवाब हां में दिया. उन्हें नया मिशन मिल गया था. नॉर्वे की सरजमीं और इसके इर्द-गिर्द फैले सर्द समंदर में नई दवाओं की तलाश का.
उन्होंने साल्मन उद्योग को बचाने की अपनी शोहरत का फ़ायदा उठाया. योर्गेंसन ने तमाम संस्थाओं से क़रीब दो करोड़ डॉलर जुटाकर, नॉर्वे का बायोडिस्कवरी प्रोजेक्ट शुरू किया. बाद में इसमें आर्कटिक बायोडिस्कवरी सेंटर के काम को भी जोड़ दिया गया.
आज योर्गेंसन के मिशन से जुड़े वैज्ञानिक, समंदर से, जंगलों से तमाम तरह की चीज़ें तलाशकर लाते हैं. इन्हें लैब में छांटा जाता है. काम की चीज़ों की ख़ूबियां पता करने के लिए उन केमिकल्स को इस प्रोजेक्ट की साझीदार निजी कंपनियों के हवाले कर दिया जाता है.
2007 से आर्कटिक सागर में अब तक 150 नए कंपाउंड तलाशे जा चुके हैं.
इनमें से कई से दुनिया को बड़ी उम्मीदें हैं. अब नॉर्वे के इस प्रोजेक्ट से जर्मनी का मैक्स प्लैंक लीड डिस्कवरी सेंटर भी जुड़ गया है. ताकि तलाशे गए हर केमिकल की ख़ूबियों की सही ढंग से पड़ताल हो सके.

इमेज स्रोत, David Wolman
बहुत सी दवा कंपनियां अब ख़ुद इस अभियान में दिलचस्पी ले रही हैं. आख़िर क़ुदरती तरीक़े से मिली दवाओं का कोई जवाब जो नहीं. फिर इन केमिकल कंपाउंड का और भी कारोबारी इस्तेमाल हो सकता है.
यानी योर्गेंसन की दूरंदेशी की वजह से आज उत्तरी ध्रुव के इलाक़े और ख़ास तौर से नार्वे के पास के समंदर, मानवता के नए रक्षक के तौर पर उभरे हैं. इनसे इंसानियत के सामने खड़ी कई चुनौतियों का हल मिलने की उम्मीद है.
(अंग्रेज़ी में मूल लेख <link type="page"><caption> यहां पढ़ें</caption><url href="http://www.bbc.com/future/story/20160506-the-arctic-gold-rush-for-tomorrows-medicines" platform="highweb"/></link>, जो बीबीसी फ़्यूचर पर उपलब्ध है.)
(बीबीसी हिन्दी के एंड्रॉएड ऐप के लिए आप <link type="page"><caption> यहां क्लिक</caption><url href="http://www.bbc.co.uk/hindi/multimedia/2013/03/130311_bbc_hindi_android_app_pn.shtml" platform="highweb"/></link> कर सकते हैं. आप हमें <link type="page"><caption> फ़ेसबुक</caption><url href="https://www.facebook.com/bbchindi " platform="highweb"/></link> और <link type="page"><caption> ट्विटर </caption><url href="https://twitter.com/BBCHindi" platform="highweb"/></link>पर फ़ॉलो भी कर सकते हैं.)












